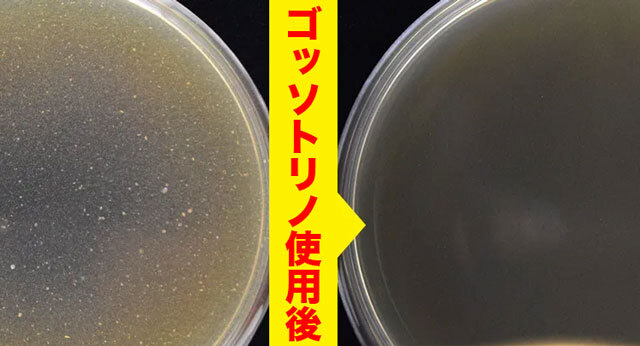

【PR】株式会社サン・クラルテ製薬





娘のことを相談することに…


激臭だったんです… 激臭レベルはMAX値の5…



という人は7割越えなのに…
* 参考:2017年 アルファネット調査結果
そのうちのほとんどが指摘はできないと回答!
* 参考:2015年 オーラルプロテクトコンソーシアム調査結果
だから娘も「臭い」と言えずひたすら我慢してたんです…

1位が口臭らしい!!

* 参考:2019年 ネオマーケティング調査結果
ただでさえ40代以降は…✅口腔内自浄作用の低下
✅加齢に伴う唾液減少
✅人工歯による雑菌増殖
⇩ ⇩ ⇩
自然と口臭が強くなる!



口臭の原因を知ってますか? 実は…大きな原因は2つ!

こびりついた舌苔
*原因菌除去
いわゆる舌の苔(コケ) 舌表面の凹凸に汚れが詰まり
こびりつくことで発生します。

蓄積した臭い玉
*原因菌除去
扁桃のくぼみに溜まった細菌の死骸や食べかすの塊。 3大悪臭物質を含んでいて
名前どおりかなりの激臭です!

自分で落としきれないこと!

口臭悪化・歯の黄ばみ・歯周炎
を引き起こすことも…! じゃあどうすれば…?

創業30年の製薬会社が開発!
*発売日2016年12月~2023年2月時点・ゴッソトリノ販売数・当社調べ
このマウスウォッシュを使った実験の衝撃結果がコチラ…

原因菌汚れがゴッソリ!

こんな汚れとれないですよね…) しかもそれだけじゃなく
臭いの数値も
5(最大レベル)⇨0(最小レベル)に!

歯周炎予防、虫歯予防 の4大効果で話題なんです!
*ブラッシング効果
歯ブラシで落せない舌苔が悩みでした。でもこのマウスウォッシュに出会って一変。15秒程口をゆすいだだけで、汚れが綺麗にとれちゃったんです。口臭も全く気にならなくなって、もう必需品です♪
*原因菌除去 *画像へイメージ *個人の感想であり効果・効能を示すものではありません。
60代男の強烈な口臭には効かないだろうと思っていましたが、数値で効果を確認できました。歯も白くなるし歯周炎予防までできるので、年代問わずオススメです。
*ブラッシング効果 *画像へイメージ *個人の感想であり効果・効能を示すものではありません。

15秒ほど口をゆすぐだけ! 吐き出すと…衝撃!

ありえない量の汚れがドバドバ…

*タンパク質汚れ


*ブラッシングによる
ひどかった口臭も…
無臭を確認できました✨! 更年期の強烈口臭を変えた
お口専用の消臭剤の正体が…


大手製薬会社が開発した… 口臭を徹底除去できる
本気のマウスウォッシュです!
*タンパク質汚れ
なぜならゴッソトリノは… 臭い玉や舌苔の原因菌汚れを分解できる
医薬部外品だから!!

効果・効能が受理された有効成分が
入っていることが条件! \しっかり認可済みです!/

口臭が簡単にゴッソリ落ちる!
*タンパク質汚れ
その効果を実感する人が続出し… ✨200万箱突破✨ 楽天3冠という偉業まで達成する実力派です。 ここまで評価されるのには
厳選した配合成分に理由が↓
【衝撃】ゴッソトリノの秘密は?
3大有効成分の配合に成功!

「シメン-5-オール」 舌苔や臭い玉の原因菌汚れを
分解・殺菌!! まとめてゴッソリ除去します!
*タンパク質汚れ
細かい成分が狭い歯と歯の間に入り込んで
汚れにしっかり届くので… 徹底的に殺菌できる!
殺菌&汚れ除去できます! さらに! 歯を白くする有効成分
「ポリリン酸」も贅沢配合!

すかさずコーティングして
再着色まで防ぎます! 口臭×ホワイトニング この2つでも十分桁違いなのに、
なんと他にも合わせて
全9つの効果を実証済!

綺麗に健康にできちゃいます! もちろん口に使うものなので
余分な成分はカット
製薬会社の徹底した品質管理
だから安心!

歯科医師も推奨するほど!

ホワイトニングやめてゴッソトリノに乗り換えました♪ おかげで白い歯だけでなく、口臭や歯周炎まで予防できてコスパが高すぎ♪個包装なので毎日持ち歩いて、口臭が気になった時や歯磨きの代わりに使用しています♪
*画像へイメージ *個人の感想であり効果・効能を示すものではありません。

口臭はもちろん、歯が白くなったのには驚きました。長年のたばこやコーヒーの蓄積まで綺麗にできるなんて…感激です!
*ブラッシング効果 *画像へイメージ *個人の感想であり効果・効能を示すものではありません。

ゴッソトリノでうがいをしたら、長年のニオイの原因をゴッソリ落とせました!もう至近距離でニオイを嗅がれても全然大丈夫!僕みたいな中年男はエチケットとして絶対使った方がいいです。
*画像へイメージ *個人の感想であり効果・効能を示すものではありません。
気になるのは値段ですよね…

【必見】最安で試す方法とは…
定価だと少々お高めなんですが… 本日 最安情報を入手!

最安特別ページをご案内!

*初回定期価格
\ さらに!!/ なんと今ならすぐに使える480円OFFクーポン配布中!

という破格で試せちゃいます!

「〇箱買わないと解約できない」
ってことはないので安心!

続けられるから嬉しい! しかも全額返金保証付き!

商品に自信があるからだそう! 超破格のうちにゲットして
ドブ臭悩みを卒業しちゃいましょ!




*ブラッシングによる



本日 緊急更新!!

と連日話題を呼んだ結果…
*タンパク質汚れ
現在注文殺到中…!! (公式ページにもこんな注意書きが…)
いつ終了するか分かりません! このキャンペーンを逃すと
1,980円(税込)も損します!

本格ケアしたいならまさにコレ!
*ブラッシング効果
とりあえず1箱お得に試して判断してみてください!



